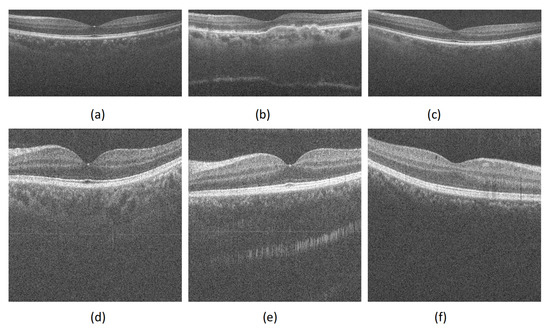

Abstract
Optical coherence tomography (OCT) is used in various fields such, as medical diagnosis and material inspection, as a non-invasive and high-resolution optical imaging modality. However, an OCT image is damaged by speckle noise during its generation, thus reducing the image quality. To address this problem, a non-local means (NLM) algorithm based on the fractional compact finite difference scheme (FCFDS) is proposed to remove the speckle noise in OCT images. FCFDS uses more local pixel information when compared to integer-order difference operators. The FCFDS operator is introduced into the NLM algorithm to construct a high-precision weight calculation so that the proposed algorithm can effectively reduce the speckle noise in the OCT images. Experiments on simulations and real OCT images show that the proposed method is comparable to other state-of-the-art despeckling methods and can substantially reduce noise and preserve image details such as edges and structures. Speckle noise removal can further promote the application of the proposed algorithm in medical diagnosis and industrial detection, as it has key research value.
Optical coherence tomography (OCT) is a non-invasive, high-precision imaging modality that is used in various fields, such as dermatology and ophthalmology [1]. However, as the OCT system uses the principle of light interference, the generated image is severely affected by speckle noise. This leads to a significantly low-quality image [2]. The layered structure and fine features of OCT images are blurred due to their low quality, which affects the accuracy of the diagnosis by the doctor [3]. An effective OCT image denoising algorithm can improve the image quality, thereby enhancing the quality of the diagnosis.
Recent researches show that either direct averaging [4] or hardware-based phase modulation [5] then averaging multiple OCT images can significantly suppress the speckle noise and enhance the OCT image quality with the cost of longer time data acquisition. However, algorithm-based speckle denoising methods are still in high demand. In addition, many despeckling algorithms have been proposed for OCT images, which are generally divided into two categories: Transform domain method and spatial domain method. Transform domain algorithms such as the wavelet shrinkage technique [6,7] and the curvelet shrinkage technique [8] usually reduce the speckle noise in OCT images by manipulating the size of the correlation coefficients. However, it is difficult to distinguish fine details from the speckle noise using the transform domain algorithms. Some artifacts may also be produced during the denoising process. Spatial domain algorithms are usually divided into local and non-local filters, such as partial differential equation (PDE) methods [9,10], non-local mean (NLM) methods [11,12,13], sparse representation (SR) methods [14,15,16,17], low-rank approximation methods [3,18,19,20], multi-frame dependent algorithms [21,22,23,24] and deep learning methods [25,26,27,28]. The deep learning method is a relatively advanced algorithm that requires a large amount of training data. The training of the deep learning models requires high-performance computing and is time-consuming. In addition, the estimated image obtained by the PDE algorithm is under-smooth, while the estimated image obtained by the SR, LRA, or multi-frame dependent algorithms are over-smooth. Hence, the NLM algorithm has attracted the attention of many scholars.
The NLM algorithm reconstructs image pixels by the weighted averaging of pixels in a predefined search window, where non-local weights are determined based on the similarity between different image patches rather than individual pixels. The NLM method, originally designed for Gaussian noise removal, has lately been applied to remove speckle noise from ultrasound images [29,30] and synthetic aperture radar images [31]. Furthermore, by designing a new weight calculation operator, some NLM-based filter filters are proposed for OCT image denoising. A double-precision NLM filter with a Gaussian anisotropic kernel function, instead of the traditional uniform kernel function, was previously proposed to effectively remove speckle noise [11]. Additionally, a two-stage NLM method using the uncorrupted probability of each pixel was introduced to suppress noise [12]. In literature [32], they have presented a novel despeckling technique for OCT, TNode, which is based on the non-local means algorithm with proper speckle statistics. This algorithm could remove the noise in the background, but it was not sufficient to remove the noise in a high-intensity region. In addition, an NLM method based on guided filtering was also proposed for the despeckling of the OCT images [13]. This algorithm could remove the noise in the background, but it was not sufficient to remove the noise in a high-intensity region [33]. An NLM method based on guided filtering was also proposed for the despeckling of the OCT images. However, these NLM-based methods could only marginally improve the performance of the despeckling system. The disadvantage of NLM methods is that they cannot accurately determine the weights using only the neighboring individual pixels. Hence, the structural similarity of noisy image blocks cannot be effectively represented. Based on existing research, it can be understood that further characterizing the topological structures as image edges and textures by substantially reducing noise and improving the robustness of the algorithm is a very critical scientific issue. To address this problem, we propose an improved NLM algorithm, which uses a fractional compact finite difference scheme (FCFDS) to accurately calculate the image similarity weight. The proposed algorithm can provide a better filtering effect, as it not only fully removes speckle noise but also effectively retains the topological structure of the image. The enhanced filtering effect can further promote the application of the OCT image data in medical diagnosis, industrial inspection, cultural relic restoration, and other fields. The improved despeckling algorithm has significant research value. The results of this study can provide important technical support for the early diagnosis and treatment of diseases. The primary aims of our research are:
(1) A template convolution operator based on the FCFDS is proposed herein. The FCFDS is a high-precision format, an extension of the compact difference format for integer-order equations. Generally, a format with higher precision implies the use of more points and a greater number of calculations. However, the FCFDS can achieve high accuracy with fewer points. Hence, using the FCFDS can reduce the computational complexity of the algorithm while maintaining its effectiveness.
(2) A bidirectional, high-precision image similarity weighting strategy based on the FCFDS is used. The information regarding the main structure of the OCT image is primarily concentrated in the horizontal and vertical directions. Therefore, to better preserve its structural information, we propose a bidirectional non-local weighting operator. In addition, we propose to use the high-precision FCFDS operator to construct the variance parameter in the vertical direction to improve the preservation of the detailed texture of the image.
(3) An OCT image denoising algorithm based on the FCFDS and NLM algorithm is proposed to remove noise while effectively preserving the structural information of the image.
The rest of the paper is organized as follows. Section 1 provides the detailed process of the proposed method. In Section 2, the simulation and real OCT images are studied, and the experimental results obtained are discussed. Section 3 concludes the paper.
1. Proposed Method
The main advantage of fractional differentiation over integer order differentiation is that fractional-order differential operators are non-local and provide an excellent tool for describing the memory and genetic characteristics of image processing. However, in the classic integer order model, the influence of fractional order differentiation is ignored [34]. In addition, the higher-order calculus derivatives and the generalized differential quadrature method can obtain higher-precision orders in the numerical solution of partial differential equations. These higher-precision orders are more conducive for applications in practical engineering calculation problems. However, the construction of higher-order derivatives or generalized differentials requires more mesh points, increasing the complexity of the algorithm and its computation Fractional differential operators have also achieved good filtering effects in image denoising, but they have fewer applications in OCT image denoising. In addition, the development of the FCFDS increases prospects for applications of the fractional derivative theory and improves the accuracy of calculations. This supports fractional calculus in the preservation of non-local image block detail information. The following two lemmas are used in the difference scheme to derive the FCFDS.
Lemma 1
([35]). Assume that , and define the shifted Grünwald difference operator by
where , β, γ, and k are constants; , is the Fourier transform of ; . Then
uniformly for as , and represents the higher-order infinitesimal of β. is the Riemann–Liouville fractional derivative, which can be expressed as:
where ε is the integral variable, and n is the smallest positive integer greater than α.
Lemma 2
([36,37]). , and its Fourier transform belong to . Defining the weighted and shifted Grünwald difference operator by
where , , , and γ, p, q are all integers. Then, we have
uniformly for as . Because of the symmetry of γ, p and q, it may be assumed that . By choosing , and , we get
According to Lemmas 1 and 2, if is the grid function space, then for any grid function , the FCFDS operator is defined as:
where .
From Equation (6), we can see that the FCFDS operator can be simplified to approximate expressions for multiplication and addition. When t for a two-dimensional image , the corresponding expressions in the horizontal x and vertical directions y directions are shown in Equations (7) and (8).
Since the structural information of the OCT images is concentrated in the horizontal and vertical directions, fractional differential masks are constructed in the directions of the positive x-coordinate and positive y-coordinate, respectively, as shown in Table 1 and Table 2. Note that is the mask coefficient of the pixel of interest. When , the fractional differential mask can be implemented. To make sure fractional differential mask has the certain center, in general, an even number is selected as N. It can be seen from Equations (7) and (8) that the mask coefficient can be expressed as:

Table 1.
Fractional differential mask on the directions of positive x-coordinate.

Table 2.
Fractional differential mask on the directions of positive y-coordinate.
For simplicity, let and . The construction of the traditional mean operator leads to the loss of image details. To better preserve the details of the image, based on the FCFDS operator, we calculate a new similarity weighted kernel function. The new weight value can be defined as
where is a pixel value at the position • from a noisy image v; is used to evaluate the similarity between the pixel intensity of two image blocks, where x and t represent two square image blocks of size . As a filtering parameter, h controls the degree of decay of the exponential function. In addition, can be represented as , where and ; can represent the image block region; represents the kernel function.
Unlike the traditional convolutional Gaussian kernel function, the new kernel function is constructed based on the FCFDS operator and contains more non-local information. can be written as:
where and ; and represent the variance parameters of the image block in the horizontal and vertical directions, respectively. Notably, the is a constant, and is determined by the FCFDS operator, and its expression is:
where is a damping coefficient, which determines the sensitivity of the value depends on and .
In this study, we use the weight function constructed by Equation (10) to obtain the filtered result image by weighted average, which is defined as
where is a set of neighborhood pixels around x, which are referred to as searching window.
To summarize, the pseudo-code of the proposed method is described in the Algorithm 1.
| Algorithm 1. Proposed method for OCT image denoising. |
|
2. Experimental Results
In order to verify the effectiveness of the algorithm, we perform noise removal experiments on real OCT retinal images, and some representative test images are shown in Figure 1. Where (a)–(c) and (d)–(f) in Figure 1 were provided online by the authors of Reference [15] and [38], respectively. Note that the DUKE dataset in Reference [15] and the PKU37 dataset in Reference [38] provide clean label images, that is, the average image of multiple adjacent images. In addition, for performing visual inspection and a quantitative comparison, the proposed algorithm was compared and analyzed against the outputs obtained after using NCDF [9], PNLM [12], WGLRR [19] and PBFD [3] four more advanced denoising algorithms.
Figure 1.
Representative images in each dataset. (a) DUKE-OCT1, (b) DUKE-OCT5, (c) DUKE-OCT7, (d) PKU37-OCT1, (e) PKU37-OCT2 and (f) PKU37-OCT9.
The quantitative indicators used include Peak Signal-to-Noise Ratio (PSNR) [39] and Structural Similarity Index Measurement (SSIM) [39]. PSNR is mainly used to measure the sharpness, contrast and clarity of images. The larger their values, the better the structure of the image such as edges and textures is preserved. SSIM is mainly used to measure the smoothness of the image. The larger their value, the greater the smoothness of the image. All the algorithms are implemented using MATLAB programming on a laptop with the following hardware specifications: 3 and 16 .
2.1. Visual Analysis of Real OCT Image Despeckling
The speckle noise removal experiment was carried out on the real OCT retinal test image, and the denoising effects of NCDF, PNLM, WGLRR and PBFD algorithms were compared. Some visual quality results after denoising are shown in Figure 2 and Figure 3.

Figure 2.
Comparison of despeckling effects of different despeckling algorithms on DUKE-OCT5 images. (a) Noisy image. (b) Clean image. (c–g) are the despeckled images obtained using the NCDF, PNLM, WGLRR, PBFD and Proposed method, respectively.

Figure 3.
Comparison of despeckling effects of different despeckling algorithms on PKU37-OCT9 images. (a) Noisy image. (b) Clean image. (c–g ) are the despeckled images obtained using the NCDF, PNLM, WGLRR, PBFD and Proposed method, respectively.
From Figure 2 and Figure 3, it can be seen that the denoising result of NCDF algorithm is compromised. Although the NCDF algorithm reduces some speckle noise on OCT image, its structure information is still blurred. In addition, the PNLM algorithms can fully remove the noise in the background area, but the high-intensity structure area still contains some noise and the layer structure information is not clear. Furthermore, one finds that the WGLRR algorithm and the PBFD algorithm can fully remove speckle noise on OCT images, but over-smoothing may lead to layer structure confusion in the edge region of the filtered image. Finally, one sees that the filtering effect of the proposed algorithm is similar to that of the WGLRR and PBFD algorithms. It can not only reduce the speckle noise in the image, but also preserve the strong and weak edge structure information and detail information of the image. The estimated image obtained by the proposed method can well preserve the edges and features in the OCT image, which is very useful for other medical image analysis, such as edge detection, image layer segmentation and clinical diagnosis.
2.2. Quantitative Analysis of Real OCT Image Despeckling
In order to more clearly show the robustness and superiority of the proposed algorithm, in addition to the previous visual effect comparison analysis, we also quantitatively analyze the filtered images of the proposed algorithm and the four comparison algorithms, and the results are shown in Table 3 and Table 4. Note that since the clean label image given in the dataset is obtained by weighted average of multiple frames, there is a certain error in the calculation of PSNR and SSIM values, but we believe that the error is acceptable.

Table 3.
The PSNR results of five different algorithms for DUKE and PKU37 test images.

Table 4.
The SSIM results of five different algorithms for DUKE and PKU37 test images.
From Table 3, one finds that the PSNR values of the proposed algorithm for DUKE and PKU37 test images are greater than the PSNR values of the NCDF and PNLM algorithms, so the smoothing effect of the proposed algorithm is better than the NCDF and PNLM algorithms. In addition, one can also see that although the PSNR mean of the proposed algorithm is lower than the PSNR mean of the WGLRR and PBFD algorithms, he difference between their values is small and the PSNR value of the proposed algorithm for some test images in the DUKE dataset is better than these two algorithms. Therefore, the smoothing effect of the proposed algorithm for DUKE test images is similar to that of WGLRR and PBFD algorithms.
From Table 4, it can be seen that the SSIM values of the proposed algorithm for DUKE test images are similar to the results of PSNR. The SSIM values of the filtered images of the proposed algorithm are greater than those of NCDF and PNLM algorithms. The SSIM values of individual images have achieved the best results, and the SSIM values of some filtered images are greater than those of the PBFD algorithm. Therefore, for the Duke dataset, the ability of the proposed algorithm to preserve the structure is better than that of NCDF and PNLM algorithms, which is comparable to WGLRR and PBFD algorithms. In addition, for the PKU37 dataset, although the proposed algorithm does not obtain the highest SSIM values, their values are not the worst, that is, the proposed algorithm can not only better reduce speckle noise but also better preserve the structural information of the image.
In summary, the proposed methods for different test images are robust and have better denoising effect. Such an output image can effectively promote its subsequent application in scientific research.
2.3. Analysis of Main Contributions
The main contribution of this paper is to propose a new kernel function based on FCFDS format, and use the new kernel function to construct high-precision weighted operator. In order to better demonstrate the effectiveness of the proposed new kernel function, we used the same algorithm and parameters to conduct denoising experiments with the traditional kernel function and the new kernel function respectively. The experimental results are shown in Figure 4 and Figure 5.

Figure 4.
Comparison of OCT denoising using different kernel functions. (a) DUKE-OCT1, (b,c) respectively represents the filtering results of image (a) using traditional uniform kernel function and FCFDS kernel function. (d) PKU37-OCT1, (e,f) represents the filtering results of image (d) using traditional uniform kernel function and FCFDS kernel function, respectively.

Figure 5.
(a) and (b) represent the PSNR and SSIM results of the proposed method and the NLM algorithm for DUKE-OCT1 and PKU37-OCT1 test images, respectively.
It can be seen from Figure 4 that the new kernel function can greatly improve the filtering results of OCT images. The filtering result of the NLM algorithm using the traditional kernel function is under-smooth. The proposed algorithm using the new kernel function can effectively reduce the speckle noise of the OCT image and preserve its structural information. In addition, from Figure 5, one sees that the PSNR and SSIM results obtained by the algorithm using the new kernel function are much larger than the NLM algorithm using the traditional kernel function. Therefore, the validity of the new kernel function is demonstrated again from the perspective of quantitative index analysis.
2.4. Visual Analysis on OCT Data
The OCT estimated image after speckle removal is an important tool for post-processing such as edge detection and segmentation. In order to further evaluate the effectiveness of the proposed algorithm, we use Canny edge detection algorithm [40] to test the edge of the denoised image. The results of image edge detection after denoising by each comparison method are shown in Figure 6.

Figure 6.
Comparison of edge detection results on denoised PKU37-OCT9 images in Figure 3. (a) Noisy image, (b) Clean image, results by (c) NCDF, (d) PNLM, (e) WGLRR, (f) PBFD and (g) Proposed method, respectively.
From Figure 6, one finds that all comparison algorithms except the NCDF algorithm can better detect strong edge information on the image. However, the filtering result of WGLRR algorithm is too smooth, weak edges and details are difficult to detect. In addition, similar to clean label images, one also observes that the PNLM algorithm, FBFP algorithm and the proposed algorithm can all detect strong and weak edges and details, but it can be seen from Figure 6 that the noise in the background region of the PNLM algorithm and FBFP algorithm is also detected. In short, through edge detection, it can be found that the proposed algorithm has well removed the noise of the image, and clearly displayed the layer structure of the image, and the weak boundary layer has been well preserved.
3. Conclusions
We proposed an NLM algorithm based on the FCFDS to reduce the speckle noise in OCT images. The proposed algorithm primarily utilizes the non-local self-similarity, statistical properties, and FCFDS operator theory of the image itself. To examine the validity of the approach applied in this study, the experimental results were compared with those published in the previous research, and a good agreement was observed between them. The experiments results revealed that:
The bidirectional high-precision image similarity weighting strategy based on the FCFDS is more effective than the traditional isotropic Gaussian similarity weighting strategy for denoising the OCT images.
Compared to some commonly used methods to remove speckle noise, our proposed method obtains the better results in both visual inspection and quantitative index analysis.
Therefore, the denoising algorithm proposed herein is expected to be applied in a wide range of biomedical imaging applications and to promote scientific research related to its subsequent processing.
Author Contributions
Conceptualization, H.C.; methodology, J.G.; software, H.C.; validation, H.C.; formal analysis, J.G.; investigation, H.C.; resources, H.C.; data curation, H.C.; writing—original draft preparation, H.C. and J.G.; writing—review and editing, H.C.; supervision, H.C.; project administration, H.C.; funding acquisition, H.C. All authors have read and agreed to the published version of the manuscript.
Funding
This research is supported in part by the National Natural Science Foundation of China (12071263, 11971269, 11971272), the Natural Science Foundation of Shandong Province of China (ZR2021QA062, ZR2019MF045), and the Doctoral Research Fund in Shandong Jianzhu University (X21052Z).
Informed Consent Statement
Not applicable.
Data Availability Statement
Data underlying the results presented in this paper are not publicly available at this time but may be obtained from the authors upon reasonable request.
Acknowledgments
Authors are grateful to D. Kermany, K. Zhang and M. Goldbaum for the release of the OCT dataset.
Conflicts of Interest
The authors have no relevant financial interest in this article and no potential conflicts of interest to disclose.
References
- Huang, D.; Swanson, E.A.; Lin, C.P.; Schuman, J.S.; Stinson, W.G.; Chang, W.; Hee, M.R.; Flotte, T.; Gregory, K.; Puliafito, C.A.; et al. Optical coherence tomography. Science 1991, 254, 1178–1181. [Google Scholar] [CrossRef] [PubMed]
- Schmitt, J.M.; Xiang, S.; Yung, K.M. Speckle in optical coherence tomography. J. Biomed. Opt. 1999, 4, 95–105. [Google Scholar] [CrossRef]
- Chen, H. Fusion denoising algorithm of optical coherence tomography image based on point-estimated and block-estimated. Optik 2021, 225, 165864. [Google Scholar] [CrossRef]
- Zhang, P.; Miller, E.B.; Manna, S.K.; Meleppat, R.K.; Pugh, E.N.; Zawadzki, R. Temporal speckle-averaging of optical coherence tomography volumes for in-vivo cellular resolution neuronal and vascular retinal imaging. Neurophotonics 2019, 6, 041105. [Google Scholar] [CrossRef] [PubMed]
- Zhang, P.; Manna, S.K.; Miller, E.B.; Jian, Y.; Meleppat, R.K.; Sarunic, M.V.; Pugh, E.N.; Zawadzki, R.J. Aperture phase modulation with adaptive optics: A novel approach for speckle reduction and structure extraction in optical coherence tomography. Biomed. Opt. Express 2019, 10, 552–570. [Google Scholar] [CrossRef]
- Adler, D.C.; Ko, T.H.; Fujimoto, J.G. Speckle reduction in optical coherence tomography images by use of a spatially adaptive wavelet filter. Opt. Lett. 2004, 29, 2878–2880. [Google Scholar] [CrossRef]
- Zaki, F.; Wang, Y.; Su, H.; Yuan, X.; Liu, X. Noise adaptive wavelet thresholding for speckle noise removal in optical coherence tomography. Biomed. Qptics Express 2017, 8, 2720–2731. [Google Scholar] [CrossRef]
- Jian, Z.; Yu, Z.; Yu, L.; Rao, B.; Chen, Z.; Tromberg, B.J. Speckle attenuation in optical coherence tomography by curvelet shrinkage. Opt. Lett. 2009, 34, 1516–1518. [Google Scholar] [CrossRef] [PubMed]
- Bernardes, R.; Maduro, C.; Serranho, P.; Araújo, A.; Barbeiro, S.; Cunha-Vaz, J. Improved adaptive complex diffusion despeckling filter. Opt. Express 2010, 18, 24048–24059. [Google Scholar] [CrossRef] [PubMed]
- Duan, J.; Lu, W.; Tench, C.; Gottlob, I.; Proudlock, F.; Samani, N.N.; Bai, L. Denoising optical coherence tomography using second order total generalized variation decomposition. Biomed. Signal Process. Control 2016, 24, 120–127. [Google Scholar] [CrossRef]
- Aum, J.; Kim, J.h.; Jeong, J. Effective speckle noise suppression in optical coherence tomography images using nonlocal means denoising filter with double Gaussian anisotropic kernels. Appl. Opt. 2015, 54, D43–D50. [Google Scholar] [CrossRef]
- Yu, H.; Gao, J.; Li, A. Probability-based non-local means filter for speckle noise suppression in optical coherence tomography images. Opt. Lett. 2016, 41, 994–997. [Google Scholar] [CrossRef] [PubMed]
- Zhou, Q.; Guo, J.M.; Ding, M.; Zhang, X. Guided Filtering based Nonlocal Means Despeckling of Optical Coherence Tomography Images. Opt. Lett. 2020, 45, 5600–5603. [Google Scholar] [CrossRef]
- Fang, L.; Li, S.; Nie, Q.; Izatt, J.A.; Toth, C.A.; Farsiu, S. Sparsity based denoising of spectral domain optical coherence tomography images. Biomed. Opt. Express 2012, 3, 927–942. [Google Scholar] [CrossRef] [PubMed]
- Fang, L.; Li, S.; McNabb, R.P.; Nie, Q.; Kuo, A.N.; Toth, C.A.; Izatt, J.A.; Farsiu, S. Fast acquisition and reconstruction of optical coherence tomography images via sparse representation. IEEE Trans. Med. Imaging 2013, 32, 2034–2049. [Google Scholar] [CrossRef]
- Huang, S.; Tang, C.; Xu, M.; Qiu, Y.; Lei, Z. BM3D-based total variation algorithm for speckle removal with structure-preserving in OCT images. Appl. Opt. 2019, 58, 6233–6243. [Google Scholar] [CrossRef]
- Zhang, X.; Li, Z.; Nan, N.; Wang, X. Denoising algorithm of OCT images via sparse representation based on noise estimation and global dictionary. Opt. Express 2022, 30, 5788–5802. [Google Scholar] [CrossRef]
- Tang, C.; Zheng, X.; Cao, L. OCT despeckling via weighted nuclear norm constrained non-local low-rank representation. Laser Phys. Lett. 2017, 14, 106001. [Google Scholar] [CrossRef]
- Tang, C.; Cao, L.; Chen, J.; Zheng, X. Speckle noise reduction for optical coherence tomography images via non-local weighted group low-rank representation. Laser Phys. Lett. 2017, 14, 056002. [Google Scholar] [CrossRef]
- Chen, H.; Fu, S.; Wang, H.; Lv, H.; Zhang, C.; Wang, F.; Li, Y. Feature-oriented singular value shrinkage for optical coherence tomography image. Opt. Lasers Eng. 2019, 114, 111–120. [Google Scholar] [CrossRef]
- Mayer, M.A.; Borsdorf, A.; Wagner, M.; Hornegger, J.; Mardin, C.Y.; Tornow, R.P. Wavelet denoising of multiframe optical coherence tomography data. Biomed. Opt. Express 2012, 3, 572–589. [Google Scholar] [CrossRef]
- Thapa, D.; Raahemifar, K.; Lakshminarayanan, V. Reduction of speckle noise from optical coherence tomography images using multi-frame weighted nuclear norm minimization method. J. Mod. Opt. 2015, 62, 1856–1864. [Google Scholar] [CrossRef]
- Lv, H.; Fu, S.; Zhang, C.; Zhai, L. Speckle noise reduction of multi-frame optical coherence tomography data using multi-linear principal component analysis. Opt. Express 2018, 26, 11804–11818. [Google Scholar] [CrossRef] [PubMed]
- Wang, C.; You, Y.J.; Ai, S.; Zhang, W.; Liao, W.; Zhang, X.; Hsieh, J.; Zhang, N.; Tang, B.; Pan, C.L.; et al. Multi-frame speckle reduction in OCT using supercontinuum pumped by noise-like pulses. J. Innov. Opt. Health Sci. 2019, 12, 1950009. [Google Scholar] [CrossRef]
- Huang, Y.; Lu, Z.; Shao, Z.; Ran, M.; Zhou, J.; Fang, L.; Zhang, Y. Simultaneous denoising and super-resolution of optical coherence tomography images based on generative adversarial network. Opt. Express 2019, 27, 12289–12307. [Google Scholar] [CrossRef] [PubMed]
- Gour, N.; Khanna, P. Speckle denoising in optical coherence tomography images using residual deep convolutional neural network. Multimed. Tools Appl. 2020, 79, 15679–15695. [Google Scholar] [CrossRef]
- Xu, M.; Tang, C.; Chen, M.; Qiu, Y.; Lei, Z. Texture preservation and speckle reduction in optical coherence tomography using the shearlet-based total variation algorithm. Opt. Lasers Eng. 2019, 122, 265–283. [Google Scholar] [CrossRef]
- Chen, Z.; Zeng, Z.; Shen, H.; Zheng, X.; Dai, P.; Ouyang, P. DN-GAN: Denoising generative adversarial networks for speckle noise reduction in optical coherence tomography images. Biomed. Signal Process. Control 2020, 55, 101632. [Google Scholar] [CrossRef]
- Coupé, P.; Hellier, P.; Kervrann, C.; Barillot, C. Nonlocal means-based speckle filtering for ultrasound images. IEEE Trans. Image Process. 2009, 18, 2221–2229. [Google Scholar] [CrossRef]
- Mei, F.; Zhang, D.; Yang, Y. Improved non-local self-similarity measures for effective speckle noise reduction in ultrasound images. Comput. Methods Programs Biomed. 2020, 196, 105670. [Google Scholar] [CrossRef] [PubMed]
- Torres, L.; Sant’Anna, S.J.; da Costa Freitas, C.; Frery, A.C. Speckle reduction in polarimetric SAR imagery with stochastic distances and nonlocal means. Pattern Recognit. 2014, 47, 141–157. [Google Scholar] [CrossRef]
- Cuartas-Vélez, C.; Restrepo, R.; Bouma, B.E.; Uribe-Patarroyo, N. Volumetric non-local-means based speckle reduction for optical coherence tomography. Biomed. Opt. Express 2018, 9, 3354–3372. [Google Scholar] [CrossRef]
- Chen, H.; Fu, S.; Wang, H.; Li, Y.; Wang, F. Speckle reduction based on fractional-order filtering and boosted singular value shrinkage for optical coherence tomography image. Biomed. Signal Process. Control 2019, 52, 281–292. [Google Scholar] [CrossRef]
- Kilbas, A.A.; Srivastava, H.M.; Trujillo, J.J. Theory and Applications of Fractional Differential Equations; Elsevier: San Diego, CA, USA, 2006. [Google Scholar]
- Meerschaert, M.M.; Tadjeran, C. Finite difference approximations for fractional advection–dispersion flow equations. J. Comput. Appl. Math. 2004, 172, 65–77. [Google Scholar] [CrossRef]
- Tian, W.; Zhou, H.; Deng, W. A class of second order difference approximations for solving space fractional diffusion equations. Math. Comput. 2015, 84, 1703–1727. [Google Scholar] [CrossRef]
- Ji, C.c.; Sun, Z.z. A high-order compact finite difference scheme for the fractional sub-diffusion equation. J. Sci. Comput. 2015, 64, 959–985. [Google Scholar] [CrossRef]
- Geng, M.; Meng, X.; Zhu, L.; Jiang, Z.; Gao, M.; Huang, Z.; Qiu, B.; Hu, Y.; Zhang, Y.; Ren, Q.; et al. Triplet Cross-Fusion Learning for Unpaired Image Denoising in Optical Coherence Tomography. IEEE Trans. Med. Imaging 2022, 44, 3357–3372. [Google Scholar] [CrossRef] [PubMed]
- Hore, A.; Ziou, D. Image quality metrics: PSNR vs. SSIM. In Proceedings of the 2010 20th International Conference on Pattern Recognition, Istanbul, Turkey, 23–26 August 2010; pp. 2366–2369. [Google Scholar]
- Canny, J. A computational approach to edge detection. IEEE Trans. Pattern Anal. Mach. Intell. 1986, 6, 679–698. [Google Scholar] [CrossRef]
Publisher’s Note: MDPI stays neutral with regard to jurisdictional claims in published maps and institutional affiliations. |
© 2022 by the authors. Licensee MDPI, Basel, Switzerland. This article is an open access article distributed under the terms and conditions of the Creative Commons Attribution (CC BY) license (https://creativecommons.org/licenses/by/4.0/).